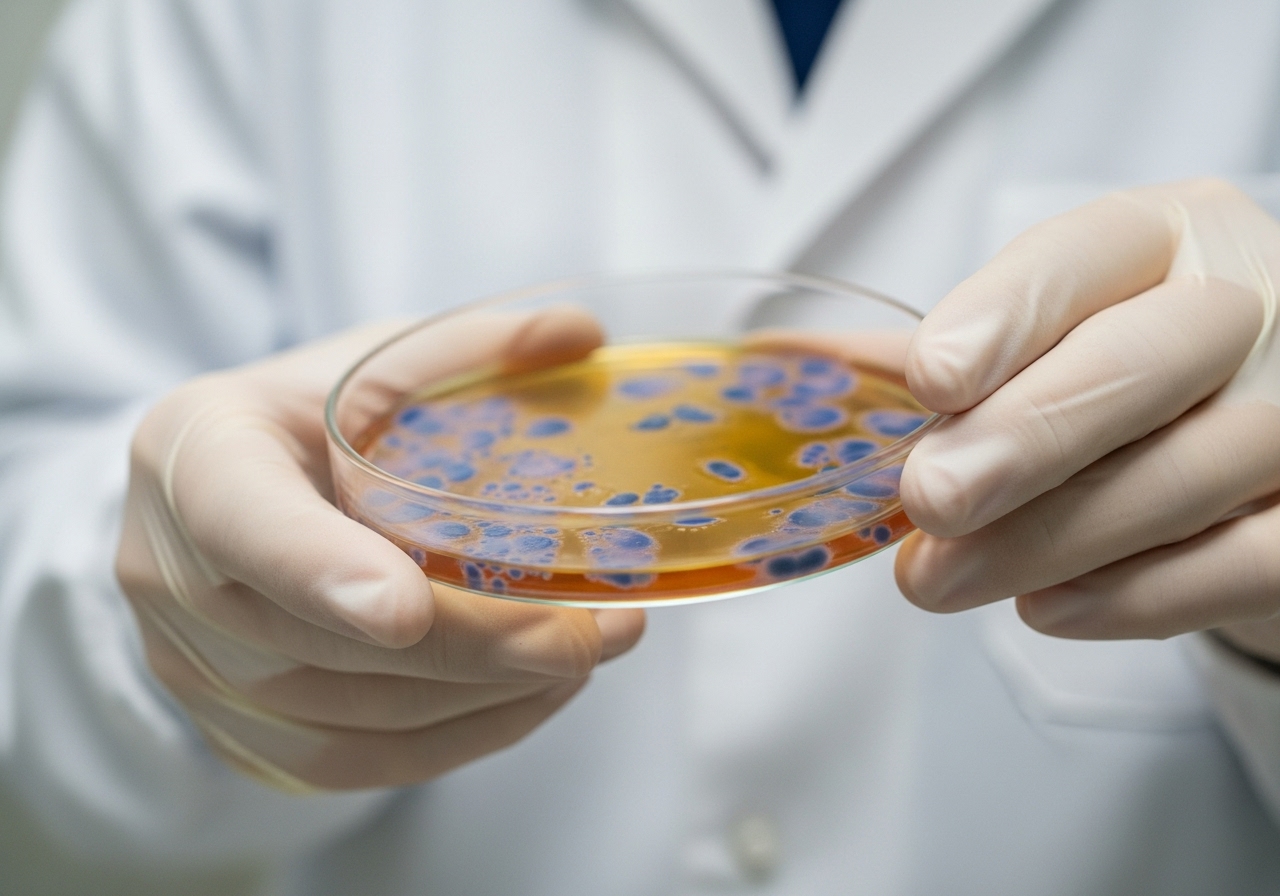
첫 번째 재료 주체를 숨기고 대상을 강조하는 문장 구조

안녕하세요, 익스 학생 여러분! 에디터 손온유(Olive)입니다.
영어 공부를 하다 보면 일상 회화와는 완전히 다른 영역을 만나게 됩니다. 바로 학술 영작문(Academic Writing)이죠. 연구 논문, 보고서, 대학 과제 등에서 요구되는 격식 있는 문체는 종종 우리를 헷갈리게 만듭니다. 그중에서도 많은 분들이 궁금해하는 부분이 바로 수동태(Passive Voice)의 사용입니다.
"수동태는 비문이거나 문장이 약해진다고 들었는데, 학술 글에서는 왜 그렇게 자주 쓰일까요?"
이 질문에 대한 답은 바로 '객관성'과 '초점'에 있습니다. 수동태는 학술 글쓰기라는 요리의 맛을 결정하는 핵심 재료입니다. 오늘은 이 수동태를 완벽하게 활용하는 학술 영작문 레시피를 단계별로 알려드리겠습니다.
첫 번째 재료 주체를 숨기고 대상을 강조하는 문장 구조
첫 번째 재료 주체를 숨기고 대상을 강조하는 문장 구조
첫 번째 재료 주체를 숨기고 대상을 강조하는 문장 구조
학술 영작문은 감정이나 개인적인 견해보다는 사실, 과정, 결과를 중시합니다. 이 때문에 문장의 주체를 '나(I)'나 '우리(We)' 같은 행위자(Agent)가 아닌, 연구의 대상이나 결과물에 두어야 할 때가 많습니다. 수동태는 바로 이 역할을 완벽하게 수행합니다.
수동태의 기본 구조는 'Be 동사 + 과거분사(P.P.)'입니다. 이 구조를 사용하면 행위자가 명확하지 않거나, 행위자보다 행위의 대상이 훨씬 중요할 때 유용합니다.
예를 들어, 실험 방법을 설명할 때 연구자가 누구인지는 중요하지 않습니다. 중요한 것은 무엇이, 어떻게 처리되었는지입니다.
❌ 능동태 (개인 주체가 강조되어 사적인 느낌을 줄 수 있음):
We analyzed the data using advanced statistical software.
✅ 수동태 (데이터 분석 과정에 초점을 맞춤):
The data was analyzed using advanced statistical software.
연구 보고서나 방법론 섹션(Methodology section)을 작성할 때, 수동태는 글의 객관성이라는 필수적인 양념을 더해줍니다. 주어를 숨김으로써 글이 개인의 작업이 아닌, 보편적인 학문적 사실처럼 느껴지게 하는 효과가 있습니다.
황금 비율 학술적 객관성을 높이는 수동태의 적절한 사용
 황금 비율 학술적 객관성을 높이는 수동태의 적절한 사용
황금 비율 학술적 객관성을 높이는 수동태의 적절한 사용
수동태를 사용할 때는 '언제 사용해야 가장 효과적인가?'라는 황금 비율을 알아야 합니다. 무분별한 사용은 오히려 문장을 복잡하게 만들 수 있습니다. 학술적 글쓰기에서 수동태가 빛을 발하는 주요 상황은 크게 세 가지입니다.
첫째, 방법론 섹션입니다. 앞에서 언급했듯이, 연구 과정 자체를 설명할 때는 수동태가 필수적입니다. 연구의 재현 가능성을 보장하기 위해 누가 했는지가 아니라, 무엇이 행해졌는지에 집중해야 합니다.
The collected samples were analyzed using mass spectrometry, and the results were compiled into a detailed report.
둘째, 결과 보고입니다. 어떤 결과가 도출되었는지를 객관적으로 전달할 때 사용됩니다.
Significant differences in growth rate were observed in the treated group compared to the control group.
셋째, 일반적인 사실이나 진술을 다룰 때입니다. 이 경우 행위자가 불특정 다수이거나, 그 중요성이 극히 낮을 때 수동태를 사용합니다.
It is widely known that global temperatures have been rising consistently over the past century.
이러한 상황에서 수동태는 글의 전문성을 높이고, 독자가 연구의 핵심 내용에 집중할 수 있도록 돕습니다. 마치 요리에서 메인 재료의 맛을 가장 잘 살리는 조리법을 선택하는 것과 같습니다.
깔끔한 마무리 'by + 행위자' 생략의 미학
 깔끔한 마무리 'by + 행위자' 생략의 미학
깔끔한 마무리 'by + 행위자' 생략의 미학
수동태를 만들 때 많은 학습자가 'by + 행위자' 구문을 습관적으로 붙이려 합니다. 하지만 학술 영작문에서는 이 'by' 구문을 생략하는 것이 더 깔끔하고 세련된 글쓰기의 비법입니다. 'by + 행위자'는 언제 생략하는 것이 좋을까요? 바로 다음 세 가지 경우입니다.
-
행위자가 불필요하거나 자명할 때: 누가 실험을 했는지(연구자), 누가 논문을 썼는지(필자)가 명확하거나 중요하지 않을 때 생략합니다.
❌ 불필요한 행위자 포함:
The literature review was conducted by the author before the experiment started.
✅ 깔끔한 생략:
The literature review was conducted before the experiment started.
-
행위자가 알려지지 않았을 때: 행위를 누가 했는지 모를 경우입니다.
Several valuable artifacts were discovered at the excavation site last month. (누가 발견했는지 모름, 또는 중요하지 않음)
-
객관성을 유지할 때: 특히 방법론 섹션에서는 'We'를 완전히 배제하기 위해 'by us'를 쓰지 않습니다.
'by + 행위자'를 생략하는 것은 학술적 글쓰기에서 간결함이라는 중요한 향신료를 더하는 행위입니다. 수동태를 사용함으로써 주체를 이미 문장 뒤로 보냈다면, 굳이 그 주체를 다시 언급하여 문장을 늘릴 필요가 없습니다. 문장의 초점이 대상에 머무르도록 유지하세요.
조리 시간 관리 능동태를 유지해야 할 순간
 조리 시간 관리 능동태를 유지해야 할 순간
조리 시간 관리 능동태를 유지해야 할 순간
수동태의 중요성을 강조했지만, 그렇다고 해서 모든 문장을 수동태로만 작성해서는 안 됩니다. 지나친 수동태 사용은 글을 딱딱하고, 때로는 모호하게 만들 수 있습니다. 모든 요리에는 적절한 조리 시간 관리가 필요하듯이, 학술 영작문에서도 능동태를 사용해야 할 결정적인 순간들이 있습니다.
1. 저자의 의견이나 해석을 제시할 때 (토론/결론 섹션): 연구자가 자신의 기여나 해석을 강력하게 주장해야 할 때는 능동태가 더 효과적입니다. 능동태는 책임감 있고 직접적인 목소리를 낼 수 있게 합니다.
We hypothesize that the new catalyst will significantly increase the reaction efficiency.
This study recommends further investigation into the environmental impact of these materials.
2. 명확성과 간결성이 최우선일 때: 수동태는 능동태보다 단어가 더 많이 필요하고(be 동사 + P.P.), 문장 구조가 복잡해지기 쉽습니다. 따라서 간단하고 직접적인 메시지를 전달할 때는 능동태가 좋습니다.
❌ 복잡한 수동태:
It is believed by the committee that the proposed solution is flawed.
✅ 명확한 능동태:
The committee believes the proposed solution is flawed.
3. 문장의 흐름을 연결할 때: 문장들이 자연스럽게 연결되기 위해서는 때때로 행위자가 명확해야 합니다. 앞 문장의 주체가 다음 문장의 행위자가 되어 문장 간의 논리적 다리를 놓을 수 있습니다.
학술 영작문의 레시피에서 수동태는 강력한 도구이지만, 과다 사용하면 글의 활력을 잃게 만듭니다. 능동태와 수동태를 6:4 또는 7:3의 비율로 혼합하여 사용하는 것이 가장 이상적인 '황금 비율'로 여겨집니다.
학술 영작문에서 수동태를 능숙하게 사용한다는 것은 단순히 문법을 아는 것을 넘어, 글의 목적과 독자를 이해하고 있다는 증거입니다. 수동태는 여러분의 연구 결과에 객관적이고 전문적인 후광을 더해주는 역할을 합니다.
익스 화상영어 수업 시간에 강사님과 함께 여러분이 작성한 연구 개요나 보고서의 문장들을 검토하며 수동태와 능동태의 균형을 잡아보는 연습을 해보세요. 능숙한 요리사처럼 문법 재료를 자유자재로 활용할 수 있게 될 것입니다.
다음에도 여러분의 영어 실력 향상에 도움이 되는 알찬 레시피를 들고 찾아오겠습니다! Happy learning!
함께 읽어볼 글

원어민의 농담을 다큐로 받아들였던 제가 익스를 만나고 완전히 달라졌어요
단어 하나하나의 뜻은 알겠는데 전체 문장은 도무지 이해가 가지 않아 당황했던 경험이 있으신가요? 비원어민을 멘붕에 빠뜨리는 미국 관용구 4가지를 알아보고 자연스럽게 대화하는 비결을 소개합니다.

SNS 피드 속에 숨겨진 원어민들의 암호를 해독하는 탐정 가이드
우리가 매일 마주하는 인스타그램과 틱톡 속에는 교과서에 나오지 않는 살아있는 영어 암호들이 가득합니다. 에디터 손온유와 함께 소셜 미디어 영어를 정복하고 진정한 인싸 영어 소통가로 거듭나는 탐정 수사 과정을 함께해보세요.

팟캐스트를 활용해 영어가 들리는 귀를 만드는 실전 가이드
무작정 듣기만 한다고 영어가 들리지 않는 이유는 학습 방식에 있습니다. 전통적인 방식과 현대적인 팟캐스트 학습의 차이를 이해하고 실전 영어를 정복하는 비결을 확인해 보세요.